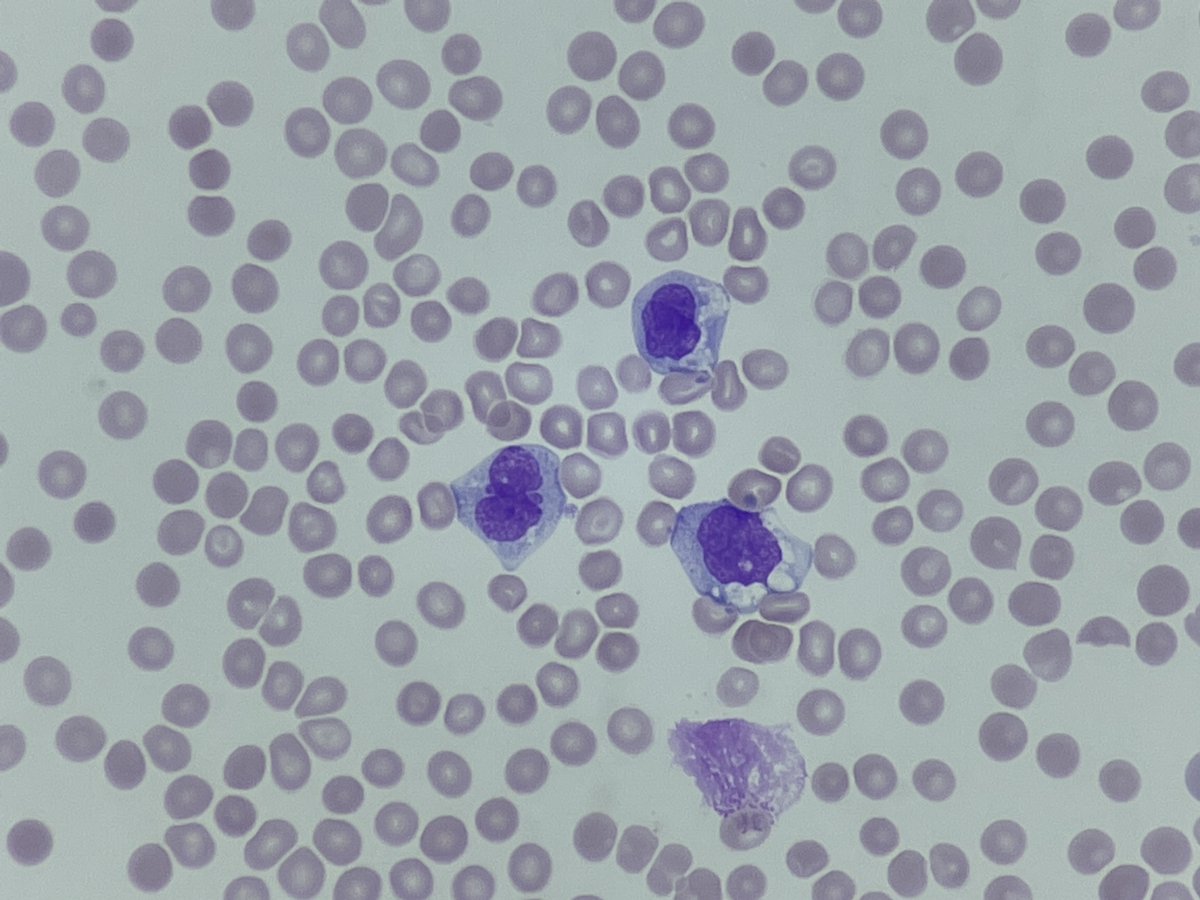
Only Cells tweet media

Myeloma is Everywhere Good Basics Matter 🧵... Keep reading🔽🔽 (Aimed for Medical Students and Early Interns) #medicine #hematology #MedEd #medtwitter #Medical #blooducation #myeloma @HaemBytes
HaemBytes
577 posts


@HaemBytes
A haematology discussion group run by haematology professionals for haematology professionals! @MorphologyAmigo @nihardesai89 @BloodScientist #HaemBytes

Myeloma is Everywhere Good Basics Matter 🧵... Keep reading🔽🔽 (Aimed for Medical Students and Early Interns) #medicine #hematology #MedEd #medtwitter #Medical #blooducation #myeloma @HaemBytes

Myeloma and PET Imaging Can share a very interesting relationship sometimes 🚨🚨Not all PETs on Myeloma patients with Lytic Lesions will be Hot ▶️▶️To Understand Why Keep Reading this 🧵 First Tweetorial for 2026 #mmsm #hematology #medicine #medtwitter #meded @HaemBytes

🩸#MorphologyMonday | Case MM250901 onlycells.co.uk/mm250901/ This week's case is from a 6 year old with chronic anaemia + jaundice + splenomegaly. Some of their laboratory results showed: - Hb: 78 g/L - MCV: 55 fL - MCHC: 365 g/L - Reticulocytes: 9% - Total Bilirubin: Elevated (predominantly indirect) - LDH: Raised - Direct Antiglobulin Test (DAT): Negative Blood film images below 👇 What do you think it could be? 🧐🤔 #LabDiagnostics #RedCell #BloodFilm #OnlyCells

